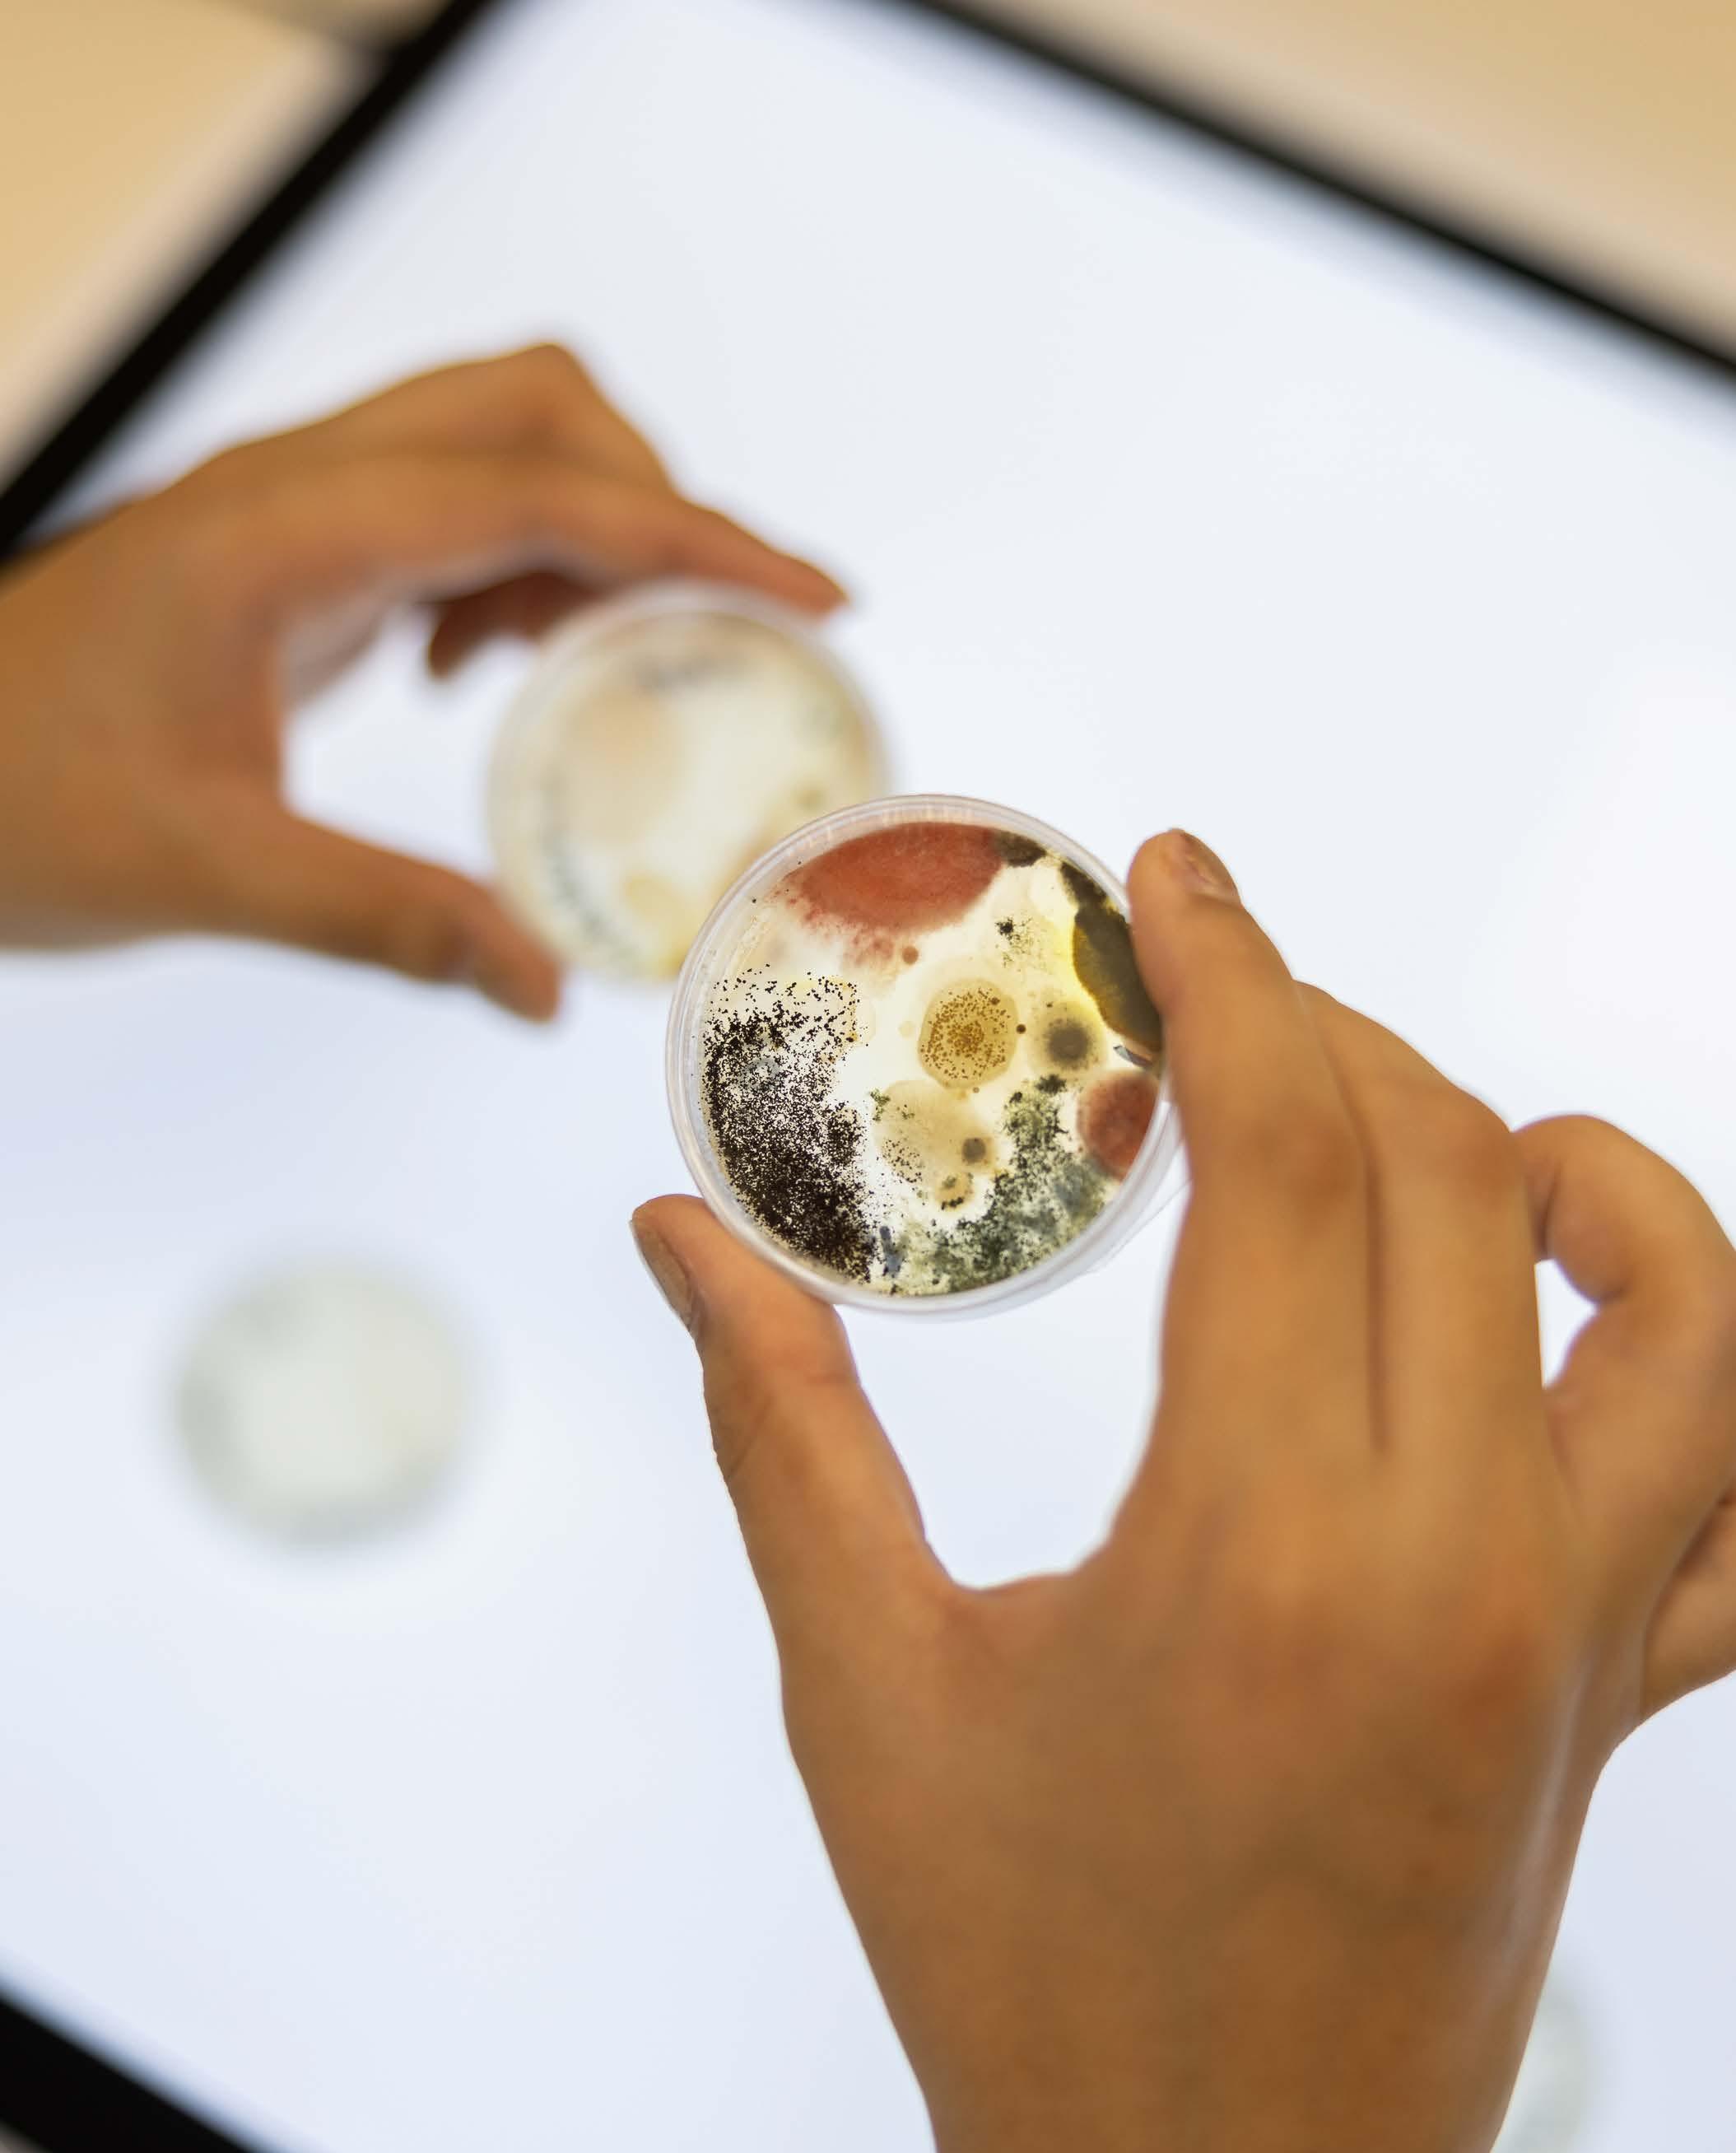

Minoren magazine 2025-2026


Minoren magazine 2025-2026

Aanbod
Avans Creative Innovation heeft een breed en vernieuwend aanbod aan minors. Alle programma’s omvatten 30 EC en vinden plaats in het najaarssemester. Studio You wordt in beide semesters aangeboden.
Het minor-onderwijs wordt gegeven door deskundige en betrokken docenten van de volgende opleidingen:
- Business Innovation
- Communication & Multimedia Design Breda
- Communicatie
- Koningstheateracademie
> Cabaret
- St. Joost School of Art & Design
> Art & Research
> New Design & Attitudes
> Illustrated & Animated Storytelling
> Photography, Film & the Digital
Hoplijk zien we jou volgend studiejaar bij een minor van Avans Creative Innovation!
Inschrijven
Inschrijven voor een minor van Avans Creative Innovation kan vanaf begin februari 2025. Het is raadzaam om je inschrijving spoedig te regelen.
Studeer je aan Avans Hogeschool, schrijf je dan in via Osiris. Je wordt hierover geïnformeerd door jouw opleiding. Studeer je aan een andere hogeschool of universiteit, schrijf je dan in via Kies Op Maat.
Voor een aantal minors geldt een toelatingsprocedure. Na inschrijving verneem je hoe de toelating verloopt.
Een deel van de minors is ook toegankelijk voor studenten uit het buitenland In dat geval staat bij de voertaal aangegeven dat deze in het Engels wordt gegeven.
Heb je vragen over de inschrijving, mail dan naar minoren.aci@avans.nl.


Onderwijsvorm: Voltijd
ECTS: 30
Location: Breda
Periode: september - januari
Transformeer jouw passie voor gaming in oplossingen met maatschappelijke impact!
Ben jij klaar om jouw creativiteit en gameontwikkelvaardigheden in te zetten voor echte maatschappelijke uitdagingen?
De B-Game Incubator - Applied Gaming is een unieke minor van de Avans Academie for Creative Innovation, waar je werkt aan innovatieve oplossingen door gaming en technologie te combineren. Duik in een inspirerende omgeving vol samenwerkingen en maak impact in de snelgroeiende wereld van applied gaming!
Waarom kiezen voor de B-Game Incubator?
• Werken op een unieke externe locatie: Tijdens deze minor werk je vanuit de indrukwekkende B’Game Incubator, gevestigd in het historische Carré-gebouw in Breda. Deze bruisende hub is dé plek waar gaming startups, creatieve makers en technologische innovators samenkomen. Je maakt deel uit van een dynamische community in het hart van het Innovatiedistrict Breda. Lees meer over deze locatie hier.
• Echte maatschappelijke impact: Werk samen met je team aan oplossingen voor stedelijke en maatschappelijke uitdagingen, zoals herontwikkeling van wijken, educatie of duurzame stedelijke groei. Jouw oplossingen kunnen fysieke, analoge of digitale games omvatten, met directe waarde voor de samenleving.
• Een toekomst in applied gaming: Ontwikkel jouw conceptuele en technische vaardigheden terwijl je leert over business development, ondernemerschap en het krachtig inzetten van serious gaming voor maatschappelijke toepassingen.
Taal: Nederlands
Toelating: Ja
Coördinator: Wouter Zaman
Wat kun je verwachten?
Tijdens deze minor dompel je jezelf onder in een creatieve en praktijkgerichte leeromgeving:
• Conceptuele fase: Duik in complexe maatschappelijke vraagstukken en ontwikkel innovatieve ideeën met een ondernemersperspectief.
• Implementatiefase: Werk aan prototypes van je game-idee en pitch deze als team aan een panel van experts. Een sterk concept staat centraal, een uitgewerkt prototype is een plus.
• Samenwerking en inspiratie: Profiteer van een breed netwerk van professionals, startups en experts binnen de B’Game Incubator, en werk samen in een ruimte die ontworpen is om creativiteit en innovatie te stimuleren.
Voor wie is deze minor?
Deze minor is ideaal voor studenten met een passie voor gaming, technologie, en maatschappelijke impact. Of je nu game-ontwikkelaar, ondernemer of creatieve denker bent, de B-Game Incubator biedt jou de ruimte en begeleiding om jouw ideeën werkelijkheid te maken.
Een toekomstgerichte visie
De B-Game Incubator is opgericht om Breda te positioneren als dé hotspot voor applied gaming en creatief ondernemerschap. Door samen te werken met de gaming-industrie, maatschappelijke organisaties en overheidsinstanties, bouwen we aan een duurzaam ecosysteem waarin games bijdragen aan oplossingen voor echte wereldproblemen.

Onderwijsvorm: Voltijd
ECTS: 30
Location: Breda
Periode: september - januari
Write LOUD is de plek waar je gevoel zijn stem laat horen en waar je ideeën handen en voeten krijgenomdat de verhalen die in je zitten er niet zijn om stil te houden. Dit is niet zomaar een minor; dit is het moment om te creëren, falen, rennen, vallen, springen en te leren je stem genoeg te vertrouwen om hem te gebruiken.
Als je kiest voor Write LOUD daag je jezelf uit om werk te maken dat nog lang naklinkt: werk met impact. Dit is een minor waarin je tools bouwt, kunt experimenteren en groeien met schrijven en je ideeën verder kunt ontwikkelen. Je ontdekt hoe je met woorden je stem laat horen en hoe je de tools voor creatief schrijven gebruikt om jezelf en je visuele praktijk uit te dagen. Je ontwikkelt je vakmanschap door uit te proberen, door feedback en reflectie, en door jezelf bloot te geven. Dit alles met als resultaat dat je werk aflevert met een kloppend hart.
In Write LOUD richten we ons op het opbouwen van je toolkit. Vaardigheden als redigeren, flow behouden, feedbacklussen, de rol van onderzoek, het vormgeven van ideeën en simpelweg komen opdagen en consequent schrijven. In deze minor ontdek je hoe je kunt schrijven op een manier die voldoet aan jouw behoeften als kunstenaar, ontwerper of maker, in de vorm van jouw keuze.
We moedigen studenten aan om hun vorm te vinden in verschillende genres en media. We delen de vele manieren waarop story building kan werken en bieden je de hulpmiddelen om je eigen aanpak te ontwikkelen. Wij zijn er vast van overtuigd dat je door meters te maken beter leert om nuance aan te brengen, spanning op te bouwen, een publiek te bereiken en betekenisvol werk te maken. Voor jezelf en voor je publiek.
Taal: Nederlands/Engels
Toelating: Ja
Coördinator: Juliet Gagnon
Voor wie is deze minor?
Je bent hongerig naar een goed verhaal en wilt degene zijn die het vertelt. Je bent bereid om zes maanden te werken aan iets waar JIJ van houdt en waar je ‘s ochtends vol enthousiasme voor uit bed komt. Je bent op zoek naar een manier om te onderzoeken hoe schrijven jouw visuele praktijk kan bevorderen of je wilt de tijd nemen om je schrijf- en vertelvaardigheden uit te breiden. Dit is een minor voor mensen met passie voor wat ze doen. Of mensen die die passie terug willen.
Wat je tijdens deze minor gaat doen:
Je gaat schrijven. Je gaat lezen. Je gaat luisteren. Je gaat je inzetten. Je zult niet perfect zijn. Je zult niet alles goed doen, maar je zult er wel zijn en je er helemaal voor inzetten.
Gedurende 20 weken ontwikkelen studenten een mediaproject (gemengd of hybride) met schrijven als basis. De vorm ligt open en je leert welke vorm jouw verhaal het beste ondersteunt (denk aan podcasts, chapbooks, graphic novels - de mogelijkheden zijn eindeloos). We werken in en buiten het leslokaal met gastdocenten uit de VS, het VK en Nederland. We werken in feedbacksessies met de groep en de kernfaculteit. De focus ligt sterk op wat de dynamiek van de GROEP voor jouw eigen werk kan betekenen, dus wees bereid om dichtbij te komen. Deze minor doe je niet alleen. Je zit niet eenzaam op je zolderkamer te schrijven, maar gaat wel leren hoe je je werk als individu kunt definiëren. Deze praktijk is gebaseerd op het besef dat kunst maken een collectieve ervaring is.
Tijdens de hele minor werk je aan een project, zoals een podcast, chapbook, graphic novel, korte beeldverhaal en meer. Onder begeleiding kies je de

vorm die het beste werkt voor jouw thema, materiaal en doelen. Je krijgt kleine, korte opdrachten en werkt intensief samen met een aantal docenten.
Tijdens de minor kom je twee keer per week samen voor boeiende sessies met gastsprekers, workshops en inspiratiedagen, ontwikkeld in samenwerking met Watershed en het Lazy Listeners Festival. Deze sessies, ontworpen om je creativiteit te stimuleren en je kennis uit te breiden, vinden plaats op locatie, online of off-site.
In het programma-overzicht krijg je precieze informatie over wanneer, wat en waar. In de loop der jaren hebben we het voorrecht gehad om als gastheer te mogen optreden voor een indrukwekkende reeks sprekers die weten waar ze het over hebben. Eerdere bijdragers waren onder andere Leonieke Baerwaldt, Corinne Heyrman, Dwight Fagbamila, Erik Jan Harmens, Mirjam van Dijk, Stan van Herpen, Buddy Wakefield, Michelle Samba, Jerron Herman en Kevin Toma. Deze zwaargewichten brengen ongeëvenaarde expertise en inzichten mee, waardoor deze minor een unieke kans is om te leren van mensen met passie.
Goed om te weten: Een aantal lessen wordt ‘s avonds en online gegeven in verband met gastcolleges uit onder meer de VS en Canada - het is verplicht om deze bij te wonen. Er zijn ook lessen in verband met het Lazy Listeners Festival op 5 en 6 december in Area 51 Eindhoven. Je aanwezigheid bij dit festival is verplicht.
Wat heb je nodig om je in te schrijven?
• Je moet van schrijven houden. Je hoeft er NIET al geweldig in te zijn, maar wel bereid zijn om te leren en open te staan voor coaching en redactionele feedback.
• Je moet een idee hebben van iets waaraan je wilt werken.
• Om te worden toegelaten, heb je een startpunt nodig. Wat is het verhaal dat je hier komt vertellen? Het kan beginnen met iets simpels als een thema, of een gebeurtenis, of iets dat je al jaren in je bureaula hebt liggen. We beginnen met een zaadje. In de toelatingsaanvraag willen we een korte beschrijving zien (200-500 woorden) van wat je wilt vertellen en waarom dit je interesseert.
• Voor deze minor is Engels lezen/spreken op B2/C1niveau vereist
• Je hoeft geen werk in het Engels te maken
Onderwijsvorm: Voltijd
ECTS: 30
Location: Breda
Periode: september - januari
Maak je je zorgen over de ecologische crisis en wil je een actieve rol spelen? Bij Material Ecologies leer je de ecologische crisis begrijpen, verbeelden en aanpakken door een combinatie van creativiteit, onderzoek en praktijk, met het materiaal als uitgangspunt. Je onderzoekt het materiële verhaal achter objecten en kunstwerken. Denk aan een houten tafel: waar komt het hout vandaan? Van winkel tot zagerij, tot het bos. Wie velde de boom, en wie verwerkte het hout?
Wat waren de ecologische relaties rond die boom?
Hoe oud was hij, en hoe zag de wereld eruit toen hij begon te groeien? En: wat gebeurt er met de tafel als hij stuk gaat—einde verhaal, of een nieuw begin?
Daarnaast kijk je naar bredere ecologische systemen. Hoe beïnvloedt jouw werk menselijk en niet-menselijk leven? Welke nieuwe verbindingen kun je maken tussen materialen, technologieën en natuurlijke processen?
In Material Ecologies werk je hands-on, in de werkplaatsen met materialen zoals hout, klei, of bijvoorbeeld textiel. En in het biolab -Material Incubator, met micro-organismen. Tegelijkertijd stellen we vragen: wat beschouwen we eigenlijk als materiaal? Zijn organismes zoals zeewieren een materiaal? Kunnen digitale data—de bits en bytes—ook een materieel narratief dragen? Door te observeren en onderzoek en het werken met je handen ontwikkel je praktische vaardigheden en vertaal je inzichten naar krachtige visuele verhalen.
Taal: Nederlands/Engels
Toelating: Ja
Coördinator: Annemarie Piscaer
Binnen de minor werken we intensief samen met het werkveld, omdat we geloven dat gedeelde kennis en samenwerking bijdragen. Zo hebben we afgelopen jaar samengewerkt met onderzoekers van Caradt, symposia gevolgd bij bijvoorbeeld Radius, het centrum voor ecologie en kunst in Delft, en werkbezoeken gebracht aan het TextielMuseum en het Europees Keramisch Werkcentrum (EKWC).
De praktijk
Onderzoek
Je onderzoekt Material Ecologies aan de hand van een aangeboden theorie en filosofie programma, en nadrukkelijk ook artistiek onderzoek.
Experimenteeren maak
Je experimenteert met verschillende materialen en werkwijzen in werkplaatsen en in het biolab.
Inspireeren communiceer
Je communiceert je onderzoek, proces en eindwerk uiteindelijk in een gezamenlijke website. Op deze manier toon je je werk in een bredere context en verbinden we ons aan het werkveld.
Laat je inspireren
Volg deze link en bekijk de projecten van studenten die de minor dit jaar hebben gevolgd.

Onderwijsvorm: Voltijd
ECTS: 30
Location: Breda
Periode: september - januari
Taal: Nederlands
Toelating: Ja
Coördinator: Sander van Bussel
Deze minor draait om social design en community art. Je maakt artistiek werk voor mensen, met mensen en tussen de mensen. Daarbij leer je om maatschappelijke impact te creëren.
Wat ga je doen?
Deze minor bestaat uit twee delen. Het eerste deel is een onderzoeksfase. Je gaat op ontdekking in de stad en verkent uitvoerig de bestaande netwerken en ecosystemen. Je gaat ontmoetingen aan met mensen van de gemeente, mensen van maatschappelijke organisaties en vooral met mensen die in de stad leven.
In de onderzoeksfase ga je op zoek naar jouw maatschappelijke betrokkenheid. Waar maak je je boos of bezorgd over? Wie zou je willen helpen? Wat wil je veranderen? Welke positie neem je in? Je onderzoek kan verschillende vormen aannemen: observeren, interviewen, meehelpen, actievoeren, je onderdompelen in een andere leefwereld, radicaal een ander perspectief innemen.
In het tweede deel van de minor zet je een eigen project op, naar aanleiding van je onderzoek. Ook dit kan vele vormen aannemen. Je kunt beeldend werk maken, een performance doen, interventies plegen, ontmoetingen organiseren en nog veel meer. De minor wordt afgerond met een manifestatie in en met de stad.
Hoe ziet het onderwijs eruit?
In deze minor werk je intensief samen met medestudenten. Je leert om samen iets bereiken dat jouw individuele mogelijkheden overstijgt.
Het onderwijs bestaat uit vaste begeleidingslessen van ervaren en betrokken docenten. Daarnaast volg je workshops en lezingen van gastdocenten.

Onderwijsvorm: Voltijd
ECTS: 30
Location: Breda
Periode: september - januari
Hoe leven we samen? Hoe werken we samen? Hoe geven we vorm aan ons samenzijn? In deze minor onderzoek je de interactie tussen het sociale aspect van samenleven en de werken die jij maakt. Je hebt de mogelijkheid om jouw ‘eigen’ atelierpraktijk voort te zetten en er is ruimte om een ‘samenwerkingspraktijk’ aan te gaan.
Tijdens de minor experimenteer je met vragen over jouw praktijk: Hoe zou deze er nog meer uit kunnen zien? Waar liggen de grenzen? Welke elementen uit jouw leven zou je ook kunnen beschouwen als onderdeel van je praktijk? Maak je muziek? Houd je van de natuur? Ben je bezig met filosofische vragen? Kook je graag? Zo kun je verschillende sferen van leven en werken organisch in elkaar laten overlopen.
Decisive here is the idea of an inessential commonality, a solidarity that in no way concerns an essence. Taking-place, the communication of singularities in the attribute of extension, does not unite them in essence, but scatters them in existence.
–Giorgio Agamben, The Coming Community (1993)
Vragen naar samenleven en samenwerken ga niet alleen intellectueel stellen, maar vooral ook belichamen. Als collectief van individuele stemmen luister je naar elkaar en wissel je ideeën uit. Je leert en “ont-leert” van en met elkaar. Dit produceert (collectieve) kennis – of niet-kennis – die je loslaat op de wereld om je heen. Dit is zorg dragen voor en het accepteren van anders-zijn, in welke vorm dan ook. Je kunt samen koken en eten, schilderen, breien, printen, tekenen, filmen, jammen, performen, teksten lezen en bespreken, tentoonstellingen bezoeken, lange wandelingen maken en nog veel meer.
Taal: Nederlands
Toelating: Ja
Coördinator: Jochem van Laarhoven
Tijdens de minor werk niet alleen samen met je klas en met de vaste docenten, maar ook met gasten die specifieke expertise inbrengen. Daarbij gaat het om diverse kunstenaars en onderzoekers uit binnenen buitenland. Ook zijn er samenwerkingen met expertisecentra van Avans.
De minor start met enkele gezamenlijke dagen in Club Solo, om elkaar te leren kennen. Ook de afsluiting vindt plaats in Club Solo. In een groepsresidentie werk je samen aan de eindtentoonstelling.
Toelatingseisen
• Je hebt je propedeuse behaald.
• Je hebt ervaring met het doorlopen van een artistiek proces.
• Je hebt belangstelling voor collectief werken en je bent gemotiveerd om daarmee te experimenteren.

Onderwijsvorm: Voltijd
ECTS: 30
Location: Breda
Periode: september - januari
Wat ga je leren?
Deze minor bij St. Joost draait om het ontwikkelen van een concept voor een geanimeerde tv-serie, een animatie film, verhalende game of voor iets dat op al deze platforms werkt.
Je leert de kern van een verhaal goed en overtuigend te vertellen, in beeld te brengen en zodoende het idee naar een professioneel pitchpakket uit te werken. Hoe maak je zo’n voorstel, waarin de combinatie van het verhaal, artwork, en teaser laat zien dat het waardig is om gerealiseerd te worden?
Om deel te nemen aan deze minor moet je een toelatingstest doen. Leerdoelen
• Ideeën helder krijgen en ontwikkelen tot een overtuigend verhaal.
• Je (technische en andere) vaardigheden ontwikkelen voor je gekozen rol.
• Een pitchpakket maken met een combinatie van verhaal, artwork, en teaser en dit professioneel presenteren.
• Verschillende vormen van visueel en theoretisch onderzoek uitvoeren.
• Beredeneerde keuzes maken voor de uitdrukkingsvorm van je idee.
• Reflecteren op je artistieke en professionele positie.
• Werken met een team in een studiosetting en
Taal: Nederlands/Engels
Toelating: Ja
Coördinator: Frank Verheggen
jouw rol daarin vinden.
• Productief omgaan met feedback van professionals.
• Werken met een grote mate van zelfstandigheid.
Wat wordt er van je verwacht?
• Je beschikt over de basiskennis en vaardigheden van visual storytelling: het vertellen van een verhaal in beelden.
• Je hebt aantoonbare interesse en basisvaardigheden in het maken van stilstaande en geanimeerde beelden. Dit kan ook een specifiek onderdeel zijn, zoals geluidsontwerp, montage of grafisch ontwerp. Je hebt ook de passie en drive om dat toe te gaan passen op deze uitingsvormen.
• Je wilt je verdiepen in conceptontwikkeling voor geanimeerde visual storytelling.
• Je hebt een actieve houding en staat open voor samenwerking.
Toelating
Toelating voor deze minor vindt plaats via een selectie op basis van een portfolio en een motivatiebrief van max. 1 A4. Als je je hebt aangemeld, ontvang je meer informatie hierover.

Assessment
Bij Development for Visual Storytelling is de beoordeling integraal. Aan het eind van de minor word je beoordeeld op:
• Visual storytelling (10 EC)
• Onderzoek & ontwikkeling (10 EC)
• Positionering (10 EC)
De final assessment kijkt naar het niveau van je werk, je onderzoek en je bijdrage tijdens de lessen.
Halverwege het programma heb je een voortgangsgesprek. Je krijgt feedback van je docenten.
Je komt te weten of je op schema ligt en wat je nog moet doen om het eindniveau te halen.
Theorie en onderzoek
Je onderzoekt je gekozen rol,het thema van het verhaal, de visuele aanpak, de technische realisatie en doelgroepen, podia en platforms.Ook reflecteer je samen op de productie.
Laat je inspireren
Volg deze link en bekijk een video over deze minor waar een aantal studenten vertellen over hun projecten.
Onderwijsvorm: Voltijd
ECTS: 30
Location: Breda
Periode: september - januari & Fefruari - Juni
Programma
Een graphic novel wordt meestal gezien als een strip met een meer volwassen karakter (maar er zijn ook graphic novels voor kinderen), qua thematiek, gelaagdheid en verhaal en is soms fictief, maar kan ook semi- of non-fictie of (auto)biografisch van karakter zijn. Maar je zou een graphic novel ook breder kunnen beschouwen als een grafisch verhaal dat gebruik maakt van de taal van het beeldverhaal of de strip op een meer persoonlijke manier. De auteur van de graphic novel is dus niet een anonieme maker, maar iemand met een eigen stem.
In deze minor ga je eerst op zoek naar welk verhaal jij wil vertellen, wat jouw taalgebruik is en hoe je dat met jouw handschrift in beeld gaat brengen. De lezer wil namelijk graag weten waarom je juist dít verhaal wil vertellen. Vorm en inhoud moeten daarvoor naadloos aansluiten bij je intenties. Je graphic novel kan tekstloos zijn of een mix van tekst en beeld, in de Nederlandse taal.
Je vertrekt vanuit je eigen handschrift en de taal van het beeldverhaal/strip, maar werkt niet binnen de generieke stijl, conventies of afspraken van een typisch stripgenre, zoals superhelden, horror, manga, of comic. Uiteraard kun je elementen uit deze genres wel als inspiratie gebruiken. Je gaat ook op zoek naar welke werkwijze het beste bij je past, dat kan vanuit een synopsis, script of scenario, maar ook meer vanuit het maken en tekenen.
In deze minor kun je kiezen: ofwel je werkt een eerste of enkele hoofdstukken uit van een omvangrijkere graphic novel, of je werkt aan een kortere graphic novel. Er wordt van je verwacht dat je je verhaal in
Taal: Nederlands
Toelating: Ja
Coördinator: Eva Hilhorst
schetsvorm uitwerkt en aan het eind van deze minor een aantal volledig uitgewerkte pagina’s en de cover kunt presenteren.
Je richt je in deze minor op de papieren markt, dus een boek, zine, of krant of iets dergelijks. Je onderzoekt ook hoe vormgeving, typografie, afmeting, papiersoort etc. nog beter bij intenties van je verhaal kunnen aansluiten, waardoor je je helder kunt positioneren binnen de markt van de graphic novels.
Je wordt begeleid door docenten van de kunstacademie St.Joost. Het accent in de begeleiding ligt op de kwaliteit en ontwikkeling van zowel de verhalende als verbeeldende kant. Daarnaast zijn er presentaties van een aantal gastdocenten, onder meer graphic novelists uit de praktijk, die ook feedback op je werk geven.
In deze minor volg je ongeveer 2,5 dagen onderwijs per week. Daarnaast werk je zelfstandig aan de projecten. Je kunt gebruikmaken van de goed uitgeruste werkplaatsen van kunstacademie St.Joost.

Leerdoelen
• In deze minor leer je een graphic novel te ontwikkelen, in een ontwerpproces van begin tot einde:
• Brainstormen op je verhaalideeën.
• Je verhaalideeën uitwerken in panels en paginalayout.
• Experimenteren met beeld(stijl) en beeld-tekst om je verhaal te maken.
• Je tekenvaardigheden verder ontwikkelen.
• Je grafische vaardigheden (typografie, opmaak, etc.) verder ontwikkelen.
• In de eindproductie een aantal pagina’s uitwerken tot een volledig eindresultaat.
Verder leer je de betekenis van characters, achtergronden (world building,) camera-standpunt, verhaallijn, kaders, kleurpalet, flow en lettering, establishing shot en cover design. En je leert hoe de uitvoering, lijnvoering, kleurgebruik, vormgeving en stijl bijdragen aan de tone of voice van de strip.
Toetsing
In deze minor is de toetsing integraal. Halverwege het programma voer je een voortgangsgesprek (formatieve beoordeling). Je ontvangt dan feedback van je docenten waaruit je kan opmaken of je op koers bent en je verneemt wat je nog moet doen om het eindniveau te behalen (summatieve beoordeling).
Aan het einde van de minor word je beoordeeld de verhalende, communicatieve en beeldende kwaliteiten van je graphic novel; op de kwaliteit van je gehele maak- en onderzoeksproces; en op de aanscherping van je profilering als visual storyteller.
Ingangseisen
• Je studeert illustratie of een aanverwante opleiding.
• Je hebt ervaring met visual storytelling: het vertellen van een verhaal in beeld. Naast tekenvaardigheden zijn generieke beeldende en verhalende kwaliteiten een must.
• Je moet durven en willen schetsen en experimenteren voor je aan de eerste fase begint.
• Je bent aantoonbaar bedreven in het maken van verhalend beeld.
• Je wilt je verdiepen in het maken een graphic novel.
• Je hebt een actieve houding en staat open voor samenwerking.
• Je hebt je propedeuse behaald.
Toelating
Toelating voor deze minor vindt plaats via een selectie op basis van een portfolio en een motivatiebrief. Als je je hebt aangemeld, ontvang je meer informatie hierover.
Onderwijsvorm: Voltijd
ECTS: 30
Location: ’s-Hertogenbosch
Periode: september - januari
Onderwerp
In deze minor van St.Joost School of Art & Design ga je in teamverband een stopmotion animatiefilm maken. Je onderzoekt je rol in het team van een stopmotionproductie en maakt samen een verhaal, waarin meerdere karakters een rol kunnen spelen. Je maakt poppen en decor op schaal en maakt daarbij gebruik van de goed uitgeruste werkplaatsen van de academie (bijv. houtwerkplaats, 3D printshop). Je volgt lessen animatie, ontdekt wat belangrijk is voor een verhaal in stopmotion en experimenteert met passend design en materiaalgebruik. Samen met je team doorloop je het hele proces van storyboard tot opname en ten slotte tot première.
Deze minor is voor studenten die houden van verhalen vertellen en van analoog werken en voor iedereen die het productieproces van een stopmotion-film wil doorlopen. En wanneer heb je nu de kans in je studie om een half jaar aan een animatie te werken?
Leerdoelen
In deze minor leer je:
• Een verhaal te ontwerpen voor een stopmotionfilm met meerdere karakters.
• Storyboarding, kadrering en camerastandpunten gebruiken.
• Bouwtekeningen maken voor karakters en set.
• Animeerbare poppen te bouwen.
• Een set op schaal te ontwerpen en te bouwen.
• Experimenteren met animatie basisvaardigheden voor stopmotion.
• Uitlichten van je set (tabletop fotografie).
• Werken met een animatiecamera en het programma Dragon Frame.
• Je rol te onderzoeken in een team.
• Samenwerken in een team.
• Basis editing, nabewerking en geluidsmontage.
Taal: Nederlands|Engels
Toelating: Ja
Coördinator: Paul Moggré
Ingangseisen
• Je studeert aan een kunstacademie of je volgt een aanverwante opleiding.
• Je hebt je propedeuse behaald.
• Je bent bereid samen te werken in een team.
• Je bent je bewust dat animatie tijd kost en geduld vraagt.
• Je beschikt over voldoende creativiteit en beeldend vermogen.
Toelating voor deze minor vindt plaats via een selectie op basis van een portfolio en een motivatiebrief van max. 1 A4. Als je je hebt aangemeld, ontvang je meer informatie hierover.

Onderwijsvorm: Voltijd
ECTS: 30
Location: ’s-Hertogenbosch
Periode: september - januari
Onderwerp
Innovatie is belangrijker dan ooit. De wereld verandert razendsnel, concurrentie is overal en de productlevenscyclus wordt korter. Innovatie is nodig: het brengt verbeteringen, oplossingen en vooruitgang: nieuwe, creatieve oplossingen voor grote en kleine problemen, gedreven door technologie of maatschappelijke issues.
Leerdoelen
Je zet jezelf neer als een deskundige, creatieve en innovatieve startende business innovator die innovaties ontwikkelt door het systematisch volgen van een innovatie proces, waarin je aantoont dat je de uitdaging kunt onderzoeken, nieuwe en innovatieve ideeën kunt genereren en concepten kunt ontwikkelen en testen. Je gebruikt hierbij passende en creatieve onderzoeksmethodes, creatieve technieken en tools, vaardigheden en kennis uit de innovatie wereld, in een multidisciplinaire, internationale en cultureel diverse context. Je doet dit met een open mind en een ondernemende, responsible en creatieve mentaliteit.
Literatuur
Lees
• Ten Types of Innovation - the discipline of building breakthroughs. Keeley, Larry ISBN 9781118504246
• Zig zag - the surprising path to greater creativity, Sawyer, Keith ISBN/EAN 9781118297704
Taal: Engels
Toelating: Ja
Coördinator: Karin van Dool
Toetsing:
Naast actieve deelname en het verwerken van workshops leveren studenten verschillende projecten, groeps- en individuele opdrachten op. Studenten tonen aan dat ze het leerresultaat hebben bereikt in een individuele presentatie en portfoliobeoordeling.
Opmerkingen
Belangrijk: De Avans-opleiding gekoppeld aan deze minormodule is: Business Innovation Den Bosch (BINNO-H)
Deze informatie heb je nodig voor het inschrijven op Studielink.

Onderwijsvorm: Voltijd
ECTS: 30
Location: ’s-Hertogenbosch
Periode: september - januari & februari - juni
Programma
Studio YOU is een minor waar je een half jaar aan de slag gaat met JOUW eigen project. Je gaat doen wat je eerder niet aandurfde.
Je bepaalt zelf de inhoud. Ervaren coaches en docenten vanuit verschillende achtergronden inspireren en pushen je om verder te gaan waar het lastig wordt. Na een half jaar presenteer je je eindwerk en je leerproces. Denk aan het realiseren van dromen zoals: een album opnemen, bijdragen aan het oplossen van een maatschappelijk probleem zoals eenzaamheid, een video- of podcastserie maken, je bedrijf naar een hoger niveau brengen... Wat je droom ook is, in deze minor ga je proberen deze tot werkelijkheid te maken.
Tijdens de minor ben je eigenaar van je eigen project. De eerste twee weken komen we intensief bij elkaar. Je maakt kennis met de andere deelnemers en je volgt een aantal workshops. Deze helpen je om stap voor stap jouw scope scherp te krijgen en om tot een concreet plan van aanpak te komen. Wie is jouw doelgroep, wie kunnen je helpen en wat heb je zelf allemaal al in huis? Inspirerende gastsprekers komen hun verhaal over het proces van de totstandkoming van hun project vertellen en wat je daarbij onderweg zoal tegen kunt komen. Daarna start de uitvoering, niets staat je meer in de weg. Je zal risico’s moeten nemen en door moeten zetten. Stilzitten is geen optie. In deze fase heb je een iedere week een bijeenkomst waarin (peer)coaching, inspiratie en feedback centraal staan. De docenten komen vanuit verschillende disciplines en bevragen en helpen je om stappen te zetten.
Je eindigt de minor met een eindpresentatie voor een zelfgekozen publiek.
Taal: Nederlands
Toelating: Ja
Coördinator: Carla Bakker
Leerdoelen
• Je kan een eigen project vormgeven en uitvoeren.
• Je kan zelf relevante stakeholders en hulpbronnen betrekken.
• Je kan jouw kwaliteiten herkennen en beoordelen.
• Je kan jouw krachten en valkuilen herkennen door persoonlijk leiderschap te nemen.
• Je kan reflecteren op je handelen en jezelf bijsturen.
Wat ga je leren?
Door zelf de regie te hebben, leer je veel over jezelf.
Het project zal een spiegel zijn waarin je jouw krachten en valkuilen gaat tegenkomen. Na de minor weet je beter wat je wilt doen na je studie en hoe je jouw dromen kan omzetten in daden. Ook durf je meer risico te nemen, je kan omgaan met weerstand en je kan effectiever samenwerken met anderen.
Ingangseisen
Dit programma past bij jou als je open en ondernemend bent én verantwoordelijkheid durft te nemen. Doe het niet als je precies van docenten wilt horen wat je moet doen!

Onderwijsvorm: Voltijd
ECTS: 30
Location: Breda
Periode: september - januari
Programma
Als professional die veranderingsprocessen kan managen en interventies kan inzetten, ben je een gewaardeerd persoon in organisaties die dynamisch moeten reageren op de veranderende omgeving. Met deze minor ontwikkel je je tot een professional die in staat is om succesvol veranderingen te begeleiden in organisaties.
Met de minor “Veranderen is mensenwerk” leer je hoe je veranderingsprocessen effectief kunt begeleiden. Je krijgt inzicht in de psychologische en groepsdynamische processen. Je ontwikkelt vaardigheden om de dynamiek van een organisatie te begrijpen en werkvormen toe te passen om in verbinding met mensen aan de slag te gaan.
Bovendien leer je hoe je met behulp van Appreciative Inquiry een organisatie kunt begeleiden bij een verandering. Deze aanpak versterkt het vermogen en vertrouwen van de mensen in de organisatie, zodat zij gezamenlijk hun ambitie kunnen bereiken.
In de ondersteunende werkcolleges, coachmomenten, gastcolleges en trainingen staan volgende onderwerpen centraal:
Psychologie en gedrag motivatie en drijfveren, weerstand, betekenisgeven, groepsdynamica, leiderschap en gedragsbeïnvloeding.
Organisatiekunde
Cultuur, structuur en het proces van verandering.
Jij als begeleider van veranderingen
Interpersoonlijke communicatie, waarderend onderzoeken, ontwerpen van praktische werkvormen, proces adviseren en begeleiden van groepen.
Taal: Nederlands
Toelating: Ja
Coördinator: Jet Schmutzer
Appreciative Inquiry
Waarderende vragen stellen, ophalen van succesverhalen, het helpen vertalen van problemen in ambities, het concreet maken van verander stappen.
Je krijgt de vrijheid om je te verdiepen in een zelfgekozen onderwerp en deel te nemen aan interactieve opdrachten. Je kiest één of twee opdrachten die jou uitdagen en samenwerking met medestudenten stimuleren.
Je werkt samen met studenten van andere opleidingen en hogescholen, een mooie interdisciplinaire ervaring.
Leerdoelen
• Je gaat in deze minor in kleine projectgroepen bij een opdrachtgever uit de praktijk aan de slag.
• Je onderzoekt het vraagstuk aan de hand van Appreciative Inquiry.
• Je betrekt zoveel mogelijk stakeholders om te achterhalen wat er daadwerkelijk aan de hand is en wat eraan gedaan kan worden.
• Je gaat experimenteren met de verschillende rollen van facilitator, onderzoeker en coach.
Toetsing
Projectrapportage en assessment.


Onderwijsvorm: Voltijd
ECTS: 30
Locatie: ’s-Hertogenbosch
Periode: september - januari
Ontdek je unieke stem in de Minor Cabaret! Ben jij een (theater)maker met een sterke roeping en wil je je eigen theatermateriaal of performance verrijken met humor? Heb je een sterk engagement, en een ambitie om vormonderzoek te doen en wil je je verder ontwikkelen in een creatieve, lerende community? Dan is de Minor Cabaret precies wat je zoekt!
De Minor Cabaret is een intensief programma waarin jij als maker centraal staat. In een veilige en inspirerende omgeving ga je op zoek naar jouw eigen cabareteske stem. Deze minor is voor studenten die de kracht van humor willen inzetten om hun verhalen te vertellen en hun publiek te raken. Of je nu al ervaring hebt met cabaret of niet, je krijgt alle tools en begeleiding die je nodig hebt om je te verdiepen in dit uitdagende vakgebied.
De focus van deze minor ligt op de ontwikkeling van de individuele maker, in de context van een groep waarin iedereen van elkaar leert. Je krijgt de kans om je eigen materiaal te maken en vorm te geven, terwijl je intensieve ondersteuning krijgt van ervaren docenten en gastartiesten. Deze begeleiding omvat zowel de ambachtelijke kant van cabaret maken — zoals het schrijven van teksten, timing en podiumperformance — als de theoretische onderbouwing. Je leert over de tradities van cabaret, de maatschappelijke impact ervan en hoe je humor op een diepere laag kunt gebruiken om je boodschap over te brengen. Kortom, de Minor Cabaret biedt jou de ruimte om je artistieke mogelijkheden te verkennen, experimenteren met vorm en inhoud, en je publiek te verrassen met jouw unieke combinatie van theater en humor. Stap in deze unieke ervaring en ontwikkel jezelf als cabaretier!
Taal: Nederlands
Toelating: Ja
Coördinator: Anna Uitdehaag
Leerdoelen
De Minor Cabaret richt zich op het ontwikkelen van humor als krachtig instrument binnen eigen theaterwerk, terwijl studenten hun persoonlijke cabareteske stijl ontdekken. Ze leren ambachtelijke cabaretvaardigheden zoals tekstschrijven en podiumprésence, gecombineerd met een theoretische onderbouwing van cabaretgeschiedenis en maatschappelijke impact. In een creatieve, lerende community leren ze samenwerken en geven/ontvangen van feedback. Daarnaast worden studenten gestimuleerd om te experimenteren met verschillende vormen en stijlen om vernieuwend en persoonlijk werk te creëren.
Toetsing
De toetsing binnen de Minor Cabaret bestaat uit een combinatie van praktijkgerichte en reflectieve opdrachten. Studenten ontwikkelen hun eigen cabaretvoorstelling, waarbij ze humor effectief inzetten en hun persoonlijke stijl tot uiting brengen. Daarnaast wordt beoordeeld op ambachtelijke vaardigheden zoals tekstschrijven, timing en podiumprésence. Theorie wordt getoetst door middel van reflectieverslagen, waarin studenten de maatschappelijke impact en geschiedenis van cabaret koppelen aan hun eigen maakproces. Samenwerking binnen de community wordt beoordeeld door peerfeedback en groepsopdrachten. Tot slot wordt vormonderzoek getoetst door het experimenteren met verschillende cabaretvormen en stijlen in het eindproduct.
Rooster
Het rooster van de Minor Cabaret wordt samen met de studenten opgesteld, zodat iedereen kan aangeven welke trainingen en workshops zij willen volgen en aan welke projecten zij willen deelnemen. Dit rooster
is flexibel en afhankelijk van de artistieke wensen van de minorstudent en diens niveau. Studenten kunnen kiezen voor een minor van 15 of 30 ECTS. De lessen vinden plaats op locatie Havensingel 25 in Den Bosch, in het eigen academiegebouw, waar een inspirerende leeromgeving wordt geboden.
Toelating
Toelating tot de Minor Cabaret vindt plaats op basis van een auditie, waarbij je je (theater)materiaal toont en een motivatiebrief indient met daarin je specifieke artistieke vraag. Na de auditie volgt een
intakegesprek waarin je jouw ambities en ideeën verder kunt toelichten. Het minimale ingangsniveau is een propedeuse op een kunstvakopleiding. Dit zorgt ervoor dat je goed voorbereid bent om de uitdagingen van de minor aan te gaan en optimaal te kunnen profiteren van de geboden mogelijkheden. Er worden per semester maximaal 5 studenten toegelaten. De Minor Cabaret kent twee startmomenten, nl. in september en in februari.
